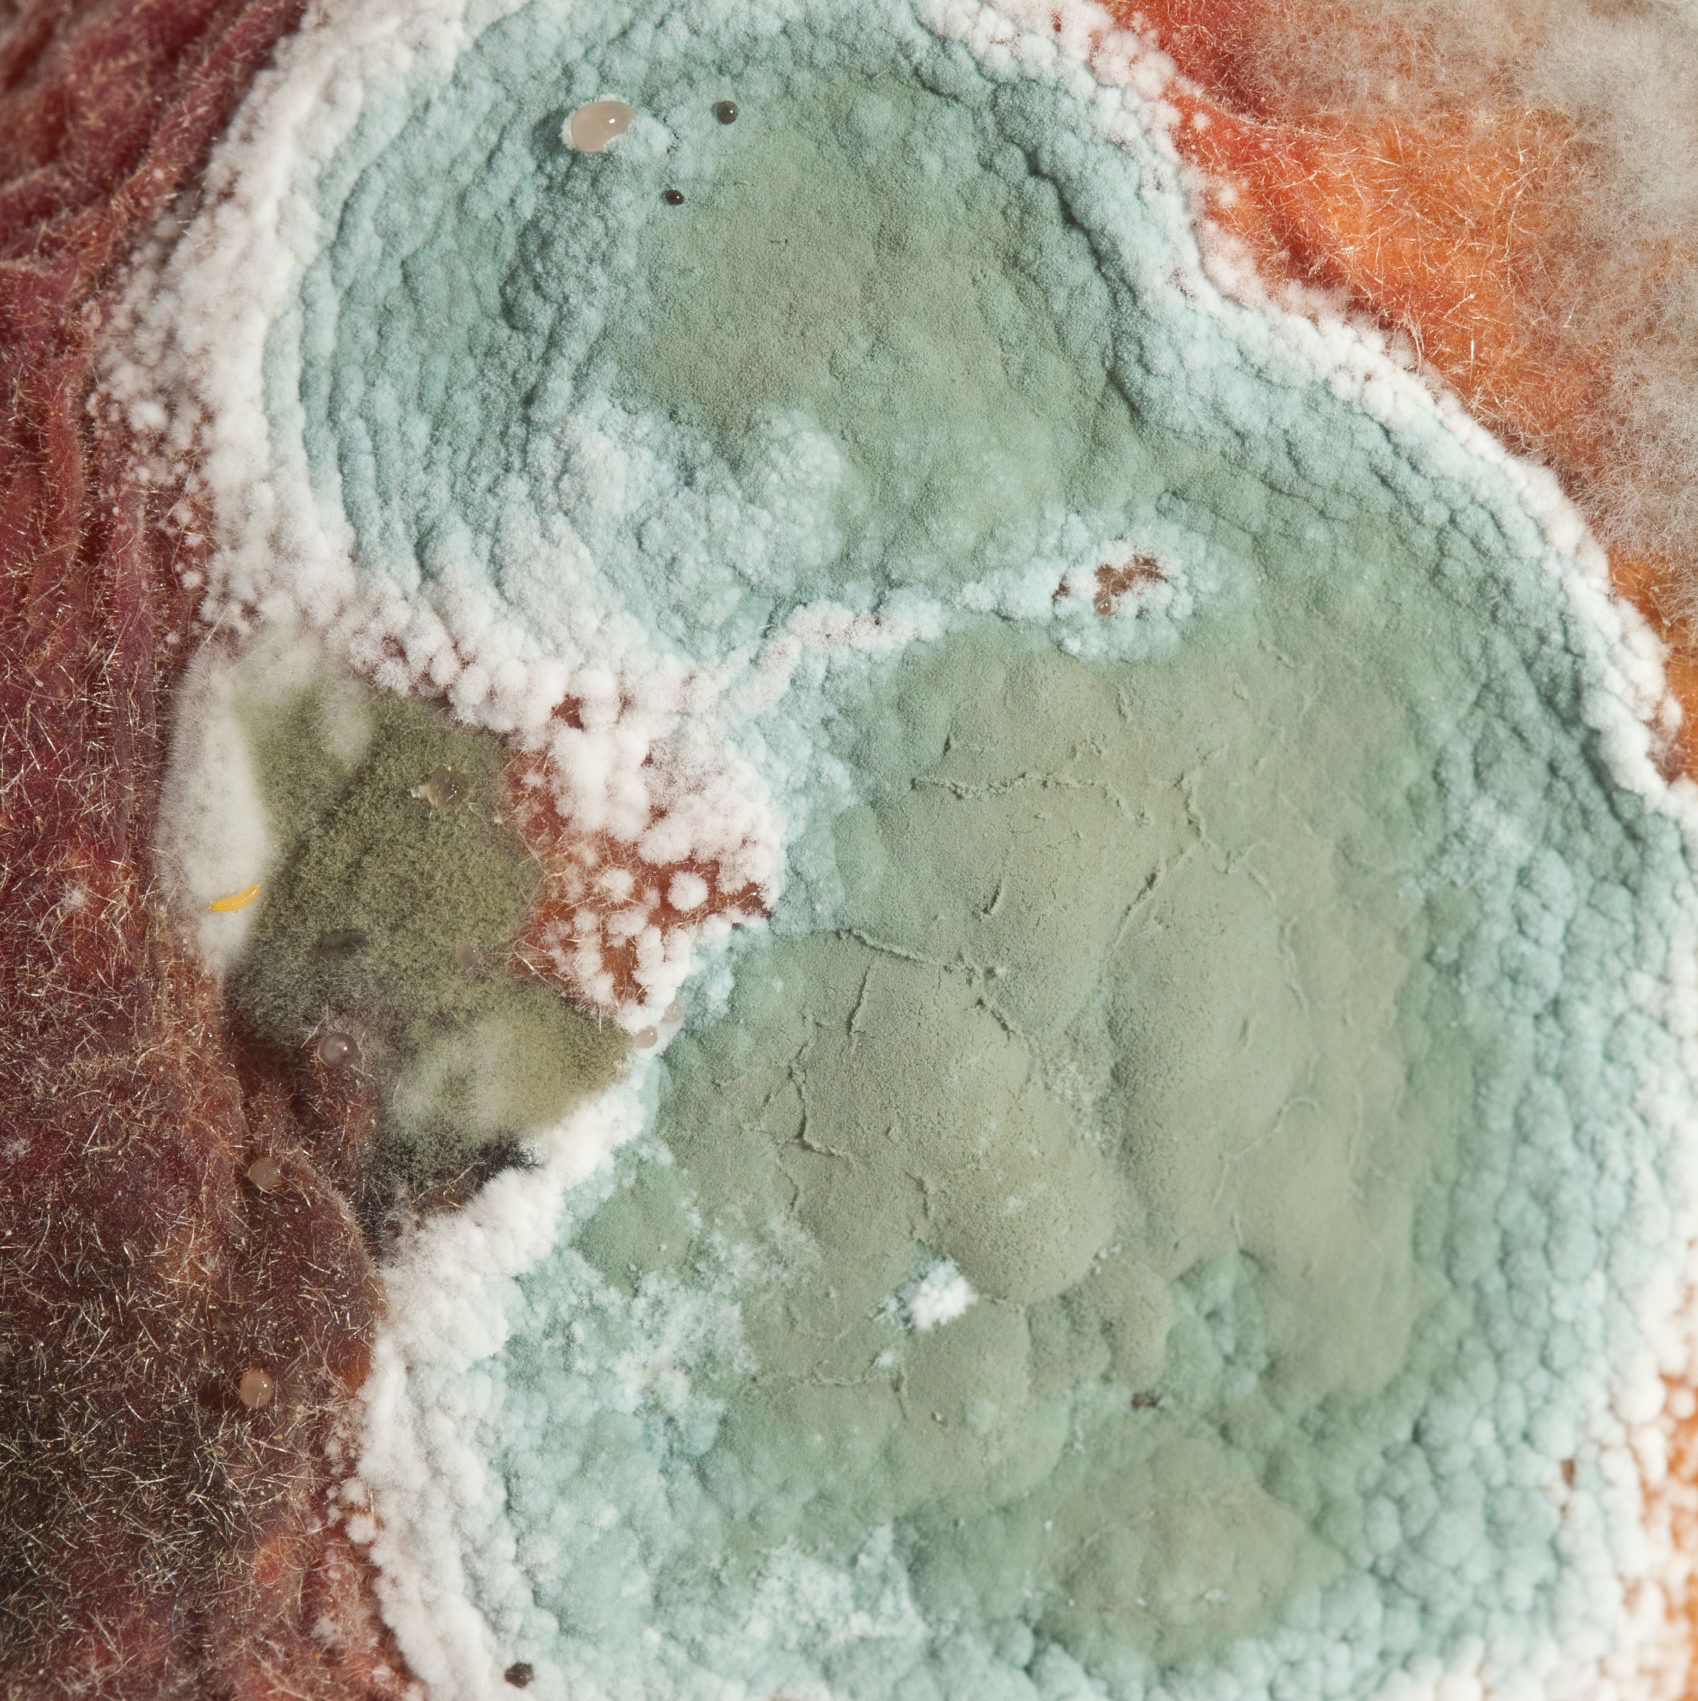

hazmat and safety pty ltd.
Identify. Assess. Remediate — Safely and Effectively.
Mould concerns?
Whether it’s a single room or a large commercial property, we’ll give you the information and confidence you need to move forward safely and prevent mould from returning.
We carry out detailed mould assessments to help you understand the extent of the issue, the underlying cause, and the safest way to remediate it. We inspect your property, identify visible and hidden mould growth, and collect samples for laboratory analysis where required.
All assessments are completed in accordance with ANSI/IICRC S520:2015 and current Australian best-practice standards. Our reports are clear, practical, and easy to follow, ensuring your property is returned to a normal, healthy indoor environment.

Office hours
Monday – Friday: 08:30 – 17:00

